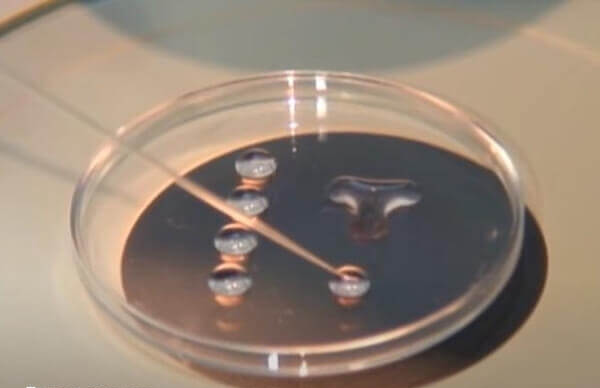
试管的成功率受到非常多因素多影响

导读: 做试管婴儿的成功率跟医生的技术有一定的关系,毕竟经验丰富的医生能根据患者身体情况,制定个性化诊疗方案,并且还拥有熟练的取卵、移植等作技巧,以此可降低对女性身体的伤害,同时还能及时发现治疗过程中的问题,不过医生技术并非是唯一决定试管成功率的因素。
做试管婴儿的成功率跟医生的技术有一定的关系,毕竟经验丰富的医生能根据患者身体情况,制定个性化诊疗方案,并且还拥有熟练的取卵、移植等作技巧,以此可降低对女性身体的伤害,同时还能及时发现治疗过程中的问题,不过医生技术并非是唯一决定试管成功率的因素。

试管成功率与医生的关系
试管的成功率高低跟主治医生的技术是有一定关系的,医生技术水平虽然并不是主导试管成功的主要因素,但试管是否成功与医生的关系也是密不可分,具体如下所示:
- 个性化方案制定:经验丰富的医生能根据患者年龄、卵巢功能、身体状况等,制定精准的促排卵方案,提高获卵质量和数量;
- 操作技术:取卵、移植等环节需医生具备熟练操作技巧,减少对身体的损伤,提高成功率。
不过如果医生技术好、经验丰富,医院设备先进的话确实可以在一定程度上提高试管的成功率,如果选择了没有资质的医生很可能连安全性都保证不了,试管的成功率更无从谈起。
影响试管成功率的因素
试管的成功率受到非常多因素多影响,医生的技术水平只是其中一方面,试管成功率主要还是与胚胎质量、女性年龄、女性身体情况以及患者情绪等相关,具体如下:
1、胚胎质量
胚胎是卵子受精后形成的,胚胎质量与男性精子质量和女性卵子质量都有关系,如果精子或卵子质量差,就会使试管成功率降低。
2、年龄
一般情况下女性35岁后体内的amh值会呈断崖式下降,受孕的成功率也会明显降低。
3、身体情况
子宫内膜容受性、宫腔环境、盆腔环境等都可以影响试管的成功率,其中子宫内膜容受性是重要的,提高内膜容受性可以提高胚胎着床的概率;
4、医生技术
如果主治医生有丰富的经验与良好的技术就会大大减少手术失误、胚胎损伤等风险。
5、情绪
不良情绪会对胎儿着床产生不良影响,建议放松心情,不要过度紧张焦虑。
试管的成功率高低跟主治医生的技术确实有一定的关系,但并不是主导试管成功与否的决定性因素,想要提高试管的成功率不仅要找一位好医生,还需要保持良好的身心状态,并提高精子、卵子质量。
下一篇:
唐山市妇幼保健院做试管婴儿要多久
标签:
好孕交流群 分享心理 链接关系 共同目标
备孕优生
助您好孕多多
不孕不育
助您好孕多多










